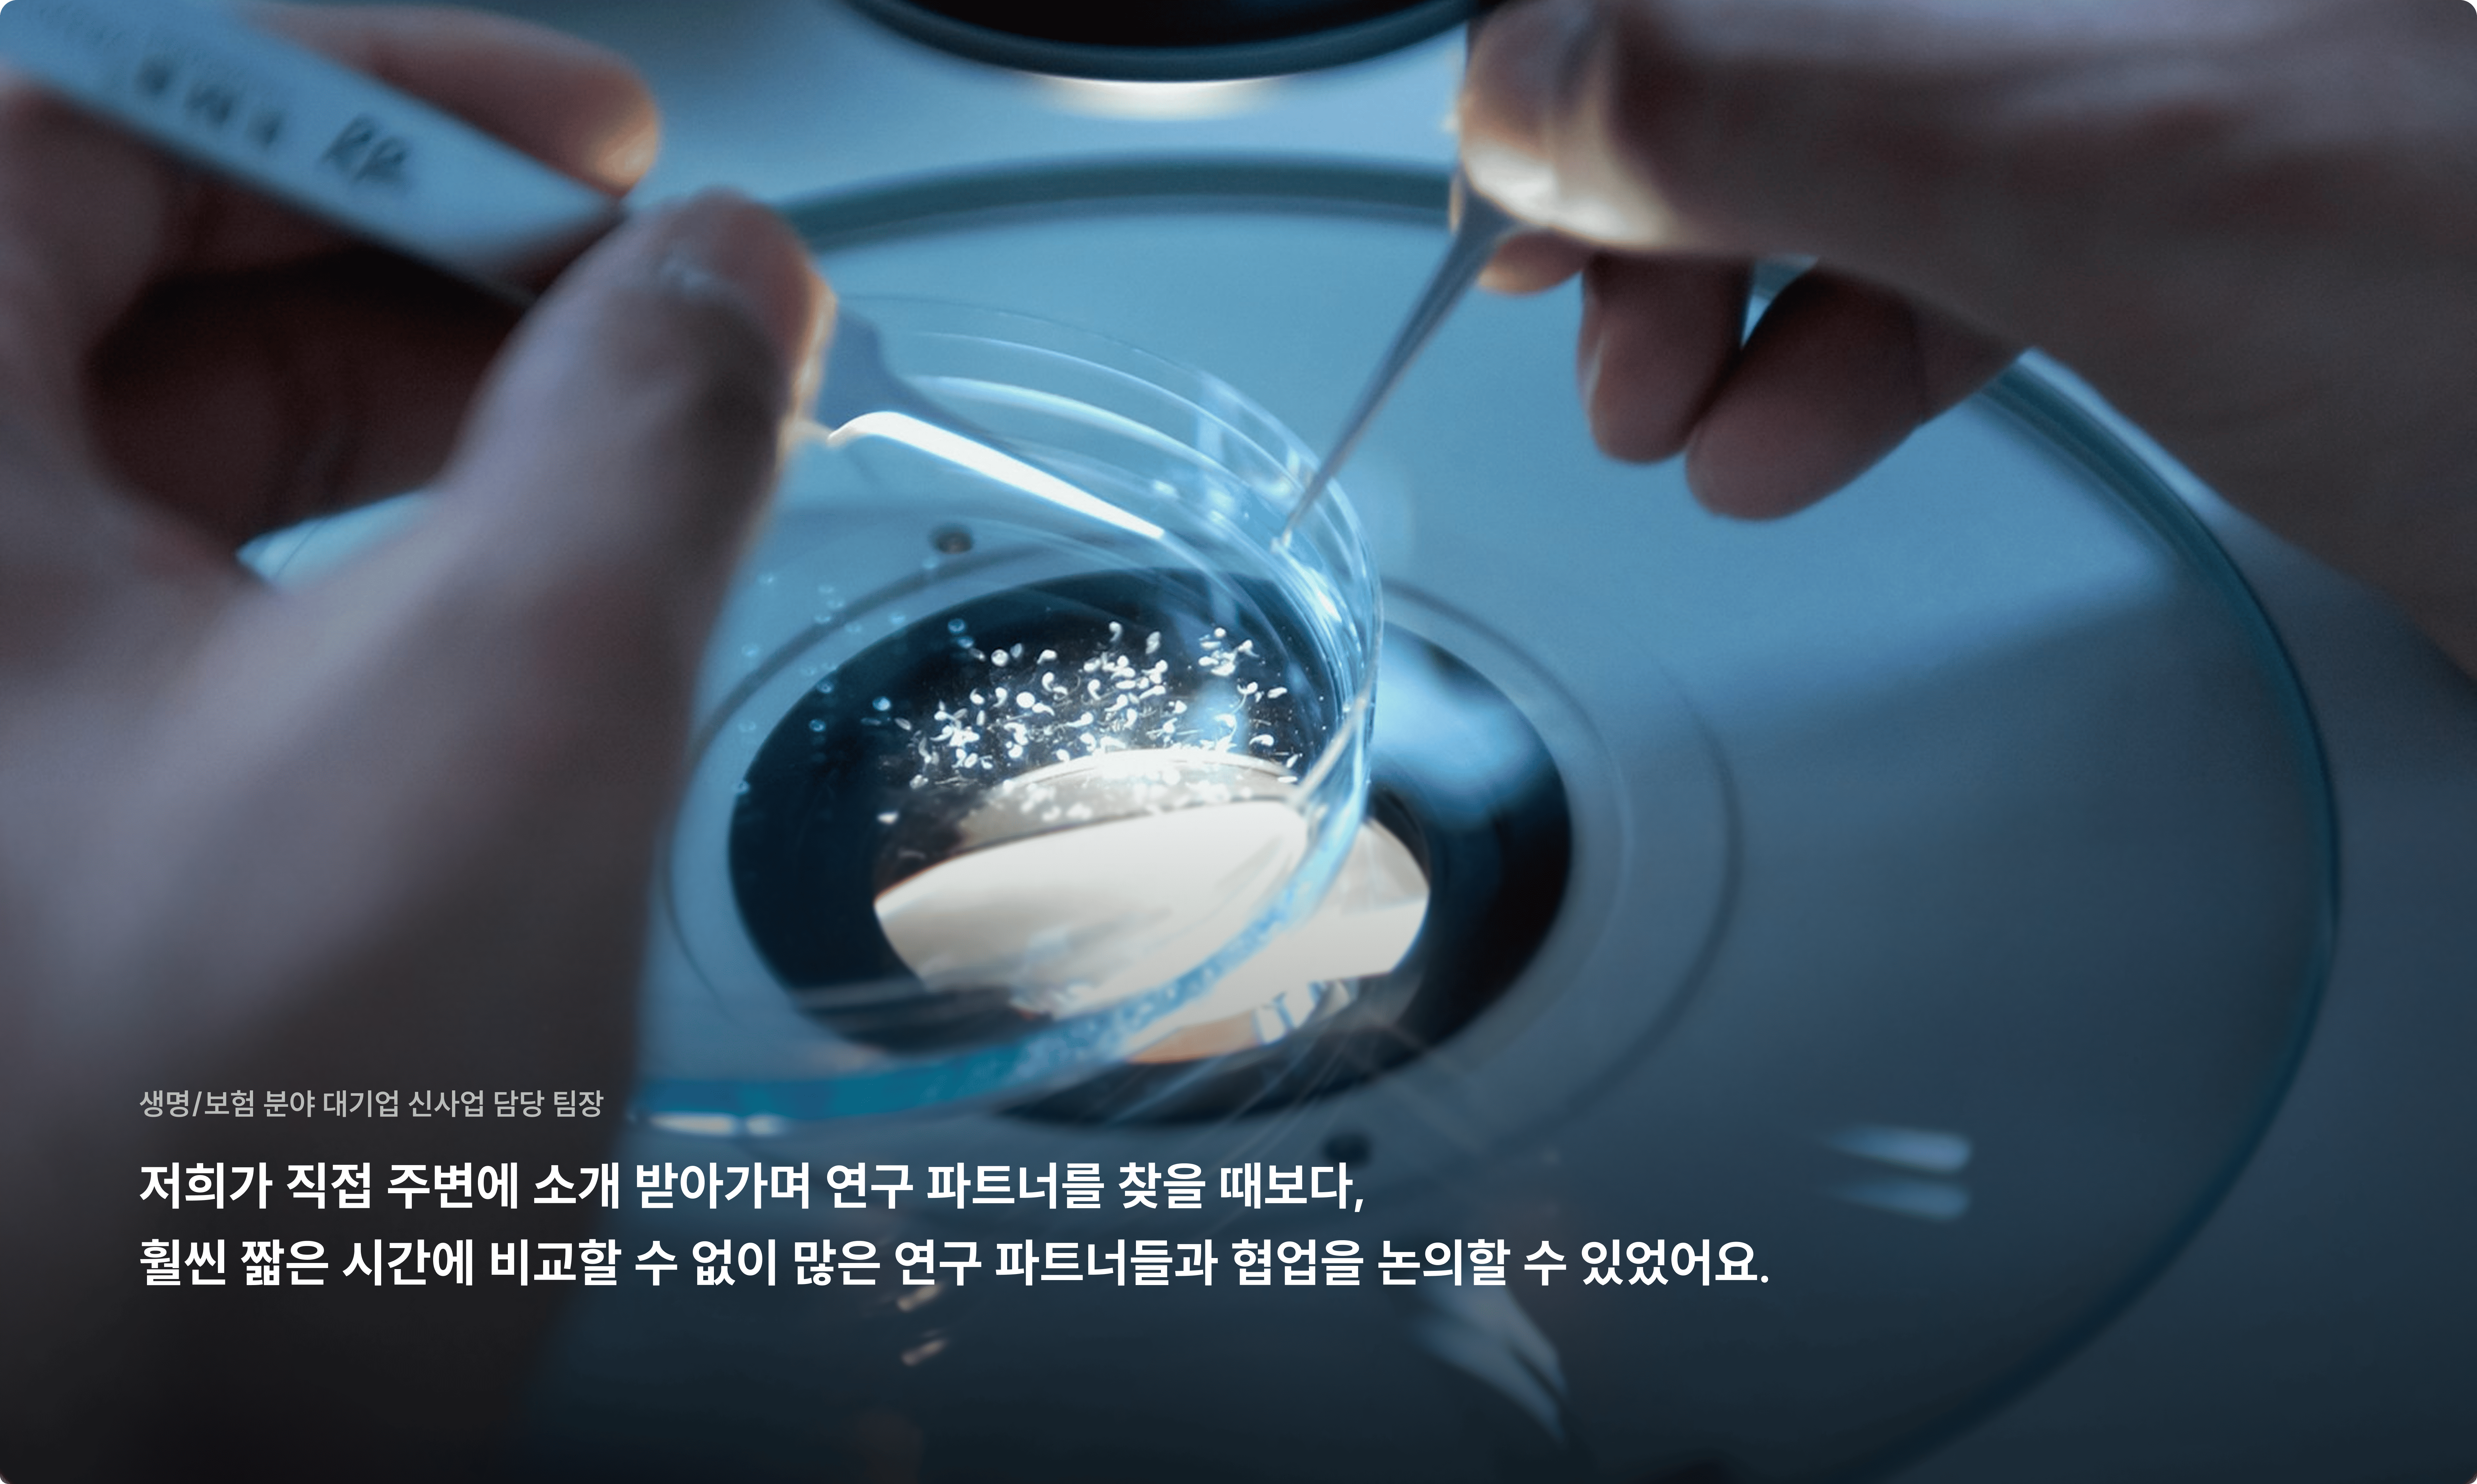

AI 기반 연구성과 PR
인공지능 기반으로, 연구실의 역량과 성과를 알리는 웹페이지와 Agent를 제공합니다.
인공지능 기반으로, 연구실의 역량과 성과를 알리는 웹페이지와 Agent를 제공합니다.



제공 가치
제공 가치
연구원은 연구에만 집중하면 됩니다. 역량과 성과를 알리고 협업 기회를 만드는 일은 AI에 맡기세요.
연구원은 연구에만 집중하면 됩니다. 역량과 성과를 알리고 협업 기회를 만드는 일은 AI에 맡기세요.
연구원은 연구에만 집중하면 됩니다. 역량과 성과를 알리고 협업 기회를 만드는 일은 AI에 맡기세요.
기존에 사용하던 연구실 웹사이트와 다양한 채널에 분산되어있는 연구자 데이터를 연결합니다. 클릭 한번에 연구실의 성과와 역량을 알리는 웹사이트가 완성되고, 방문자의 특성에 따라 연구실을 맞춤형으로 설명하고 협업 기회를 만들어냅니다.
기존에 사용하던 연구실 웹사이트와 다양한 채널에 분산되어있는 연구자 데이터를 연결합니다. 클릭 한번에 연구실의 성과와 역량을 알리는 웹사이트가 완성되고, 방문자의 특성에 따라 연구실을 맞춤형으로 설명하고 협업 기회를 만들어냅니다.
기존에 사용하던 연구실 웹사이트와 다양한 채널에 분산되어있는 연구자 데이터를 연결합니다. 클릭 한번에 연구실의 성과와 역량을 알리는 웹사이트가 완성되고, 방문자의 특성에 따라 연구실을 맞춤형으로 설명하고 협업 기회를 만들어냅니다.



클릭 한 번에 웹페이지 완성
클릭 한 번에 웹페이지 완성
클릭 한 번이면, 연구실의 기존 사이트와 논문/프로젝트/특허 등 분산되어있는 R&D 정보들을 자동으로 연결하여 연구실 전용 웹페이지를 만들어드립니다.



월 10만명이 방문하는 플랫폼
월 10만명이 방문하는 플랫폼
월 평균 10만 명 이상의 기업 R&D 담당자와 다양한 기관 및 대학의 연구원들이 연구실 정보와 프로젝트 기회를 탐색하기 위해 방문하고 있습니다. 해당 플랫폼 내에서 연구실 정보를 적극적으로 노출시켜 협업 기회를 만들어냅니다.



방문자 맞춤형으로 연구 내용 소개
방문자 맞춤형으로 연구 내용 소개
인공지능 기술을 활용하여, 개별 방문자의 유형과 관심사에 맞춰서, 어렵고 복잡한 연구 내용과 성과들을 알기 쉽고 관련도 높은 맞춤형 콘텐츠로 만들어 제공합니다.
주요 기능 소개
주요 기능 소개
연구실의 역량과 성과를 개별 방문자 맞춤형으로 전달
연구실의 역량과 성과를 개별 방문자 맞춤형으로 전달
연구실의 역량과 성과를 개별 방문자 맞춤형으로 전달
연구실 웹페이지
다양한 채널에 흩어져있는 연구실 데이터를 연동하여 최적의 성과 홍보 웹페이지를 만들어드립니다.
맞춤형 콘텐츠화
연구실의 주요 연구 내용과 논문 및 프로젝트 성과들은 개별 방문자의 특성에 맞춰서 콘텐츠화되어 제공됩니다.
AI Agent (기회 발굴)
학습한 연구실 데이터를 기반으로, 개별 기업 담당자에게 연구실과의 협업 시나리오와 특장점을 실시간 맞춤형으로 제공합니다.
검색 노출 확보
외부 검색 포탈 및 월 10만명의 기업 R&D 담당자와 연구원이 방문하는 검색 서비스에 연구실 정보를 게재하여 노출량을 확보합니다.

연구실 웹페이지
다양한 채널에 흩어져있는 연구실 데이터를 연동하여 최적의 성과 홍보 웹페이지를 만들어드립니다.

맞춤형 콘텐츠화
연구실의 주요 연구 내용과 논문 및 프로젝트 성과들은 개별 방문자의 특성에 맞춰서 콘텐츠화되어 제공됩니다.


AI Agent (기회 발굴)
학습한 연구실 데이터를 기반으로, 개별 기업 담당자에게 연구실과의 협업 시나리오와 특장점을 실시간 맞춤형으로 제공합니다.

검색 노출 확보
외부 검색 및 월 10만명의 기업 R&D 담당자와 연구원이 방문하는 검색 서비스에 연구실 정보를 게재하여 노출량을 확보합니다.
연구실 웹페이지
다양한 채널에 흩어져있는 연구실 데이터를 연동하여 최적의 성과 홍보 웹페이지를 만들어드립니다.

맞춤형 콘텐츠화
연구실의 주요 연구 내용과 논문 및 프로젝트 성과들은 개별 방문자의 특성에 맞춰서 콘텐츠화되어 제공됩니다.


AI Agent (기회 발굴)
학습한 연구실 데이터를 기반으로, 개별 기업 담당자에게 연구실과의 협업 시나리오와 특장점을 실시간 맞춤형으로 제공합니다.

검색 노출 확보
수행을 희망하는 정부 과제가 있다면, 해당 과제를 함께 수주/수행할 최적의 파트너와 매칭해드립니다.
서비스 체험
서비스 체험
지금 바로 무료로 체험해보세요
지금 바로 무료로 체험해보세요
솔루션 도입 효과
솔루션 도입 효과
어렵고 복잡한 연구 내용과 성과를 방문자 맞춤형으로 설명
어렵고 복잡한 연구 내용과 성과를 방문자 맞춤형으로 설명
어렵고 복잡한 연구 내용과 성과를 방문자 맞춤형으로 설명
우수한 연구 역량과 성과들이 효과적으로 알려져서 새로운 연구 기회 창출과 연구원 리크루팅에 적극적으로 활용될 수 있도록 합니다.
우수한 연구 역량과 성과들이 효과적으로 알려져서 새로운 연구 기회 창출과 연구원 리크루팅에 적극적으로 활용될 수 있도록 합니다.
우수한 연구 역량과 성과들이 효과적으로 알려져서 새로운 연구 기회 창출과 연구원 리크루팅에 적극적으로 활용될 수 있도록 합니다.
기존
기존
교수님 혹은 연구원이 직접 연구실 웹사이트 제작/운영
교수님 혹은 연구원이 직접 연구실 웹사이트 제작/운영
각기 다른 채널에서 연구실 정보 입력하고 관리
각기 다른 채널에서 연구실 정보 입력하고 관리
아무도 찾아오지 않는 연구실 웹사이트
아무도 찾아오지 않는 연구실 웹사이트
어렵고 복잡한 연구 내용과 성과를 제한적으로 제공
어렵고 복잡한 연구 내용과 성과를 제한적으로 제공
RnDCircle
RnDCircle
클릭 한 번에, 성과 홍보에 최적화된 웹사이트 완성
클릭 한 번에, 성과 홍보에 최적화된 웹사이트 완성
클릭 한 번에 분산된 데이트 통합
클릭 한 번에 분산된 데이트 통합
월 10만명의 기업 담당자와 학생이 찾아오는 플랫폼에 노출
월 10만명의 기업 담당자와 학생이 찾아오는 플랫폼에 노출
주요 연구 내용과 성과를 개별 방문자 맞춤으로 콘텐츠화
주요 연구 내용과 성과를 개별 방문자 맞춤으로 콘텐츠화
서비스 성과
서비스 성과
스타트업부터 대기업까지, 디써클의 서비스를 통해 최적의 R&D 파트너와 만나고 있습니다.
스타트업부터 대기업까지, 디써클의 서비스를 통해 최적의 R&D 파트너와 만나고 있습니다.
기존의 비효율적이고 불투명한 인적 네트워크 중심의 과정을 데이터와 인공지능 기반의 효율적인 프로세스로 대체합니다.
기존의 비효율적이고 불투명한 인적 네트워크 중심의 과정을 데이터와 인공지능 기반의 효율적인 프로세스로 대체합니다.










고객사 인터뷰
고객사 인터뷰
RnDcircle과 함께하고 있는 다양한 고객사들의 이야기를 들어보세요
RnDcircle과 함께하고 있는 다양한 고객사들의 이야기를 들어보세요
자주 묻는 질문
Q01.
AI 기반 연구성과 PR 서비스를 이용하려면 어떻게 해야 하나요?
Q01.
AI 기반 연구성과 PR 서비스를 이용하려면 어떻게 해야 하나요?
Q1.
AI 기반 연구성과 PR 서비스를 이용하려면 어떻게 해야 하나요?
Q02.
웹페이지는 어떤 방식으로 타겟에게 노출되나요?
Q02.
웹페이지는 어떤 방식으로 타겟에게 노출되나요?
Q2.
웹페이지는 어떤 방식으로 타겟에게 노출되나요?
Q03.
연구실 웹페이지를 외부에서 활용할 수 있나요?
Q03.
연구실 웹페이지를 외부에서 활용할 수 있나요?
Q3.
연구실 웹페이지를 외부에서 활용할 수 있나요?
기업 서비스